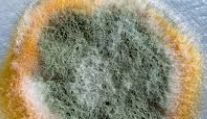

곰팡이 제거방법 요즘 많이 궁금하시죠. 장마철에는 가장 신경 쓰이는 부분이 바로 높은 습기로 인한 곰팡이입니다. 오늘은 집구석구석 필요한 곰팡이에 대한 정보와 그에 맞는 곰팡이 제거방법에 대하여 포스팅하겠습니다.
요즘 곰팡이가 많이 생겨서 곰팡이에 대한 정볼르 검색하는 경우가 많아졌습니다. 이유는 벽과 옷장 그리고 창틀에 곰팡이가 생기고 확산이 되는 게 눈에 띄게 보이는 경우가 많아졌기 때문입니다. 그리고 곰팡이는 이상한 냄새까지 발생하게 됩니다.
집을 책임지는 주부들은 고민이 많을 겁니다. 그래서 제습기에 대한 구매도 높아지고 있습니다. 하지만 이미 발생한 곰팡이는 빠르게 없애주어야 하는 것이 가족 모두의 건강을 위해 좋습니다.

곰팡이 제거방법
곰팡이는 무엇일까요? 곰팡이는 균의 한 종류입니다. 세상에는 수천 종의 균들이 존재하고 그중에 높은 습기에 빠르게 번식하는 균의 종류를 집에서 곰팡이라 부르고 있습니다. 하지만 세균과는 다른 의미를 가지고 있습니다.
곰팡이는 공기 중에 포자가 떠다니다가 습기가 높은 곳에 달라붙어 번식을 시작합니다. 장마철 같은 높은 습도가 유지되는 계절에는 그래서 많이 보게 된 것입니다. 한번 번식이 되면 빠르게 번지기 시작하며 집안 곳곳을 곰팡이로 물들게 만듭니다.
일부 곰팡이는 진균 독을 가지고 있어 가족의 건강에 위험을 발생시킬 수도 있습니다. 그래서 집에 곰팡이가 보이기 시작하면 빠르게 없애주고 습도를 낮추어 주는 것이 가장 중요합니다.

곰팡이 예방
한번 얼룩진 곰팡이는 제거를 한다고 해도 여간 골칫거리가 아닙니다. 곰팡이에 대한 우려가 된다면 가장 좋은 제거방법은 역시 곰팡이를 예방하여 처음부터 곰팡이가 생기는 환경을 차단하는 거입니다.
곰팡이 제거가 어렵다면, 아예 처음부터 곰팡이가 생기지 않도록 예방하는 것이 제일 좋은 방법입니다.
- 집안 습도 낮추기.
- 환기 자주 하기.
- 햇빛 가리지 않기.
- 자주 청소하기
가장 먼저 해야 하는 일은 습도를 줄이는 것입니다. 그러면 곰팡이 발생을 손쉽게 예방할 수 있습니다. 그리고 곰팡이가 생기지 않도록 자주 집안 전체 환기를 하는 습관을 가져야 합니다. 집 안공 기를 바깥으로 배출하고 순환시키는 것이 곰파이 제거에 아주 도움이 됩니다.
특히 햇빛이 잘 들어오는 창문은 최대한 자주, 활짝 열어주면 집안 곰팡이 예방에 가장 좋습니다. 곰팡이는 습기가 높은 공간에서 자주 발생하기 때문에 습기를 낮추는 방법을 생각해야 합니다. 그리고 햇빛에 곰팡이는 약하기 때문에 채광이 잘되도록 커튼을 낮에는 하지 않는 것이 좋습니다.
욕실은 환풍기가 제대로 작동하는지 체크하고 이용하지 않아도 환풍기를 자주 틀어주는 것이 좋습니다. 그리고 욕실은 물로 자주 청소해주는 것도 좋은 방법입니다.



종류별 곰팡이 제거방법
곰팡이가 자주 발생하는 곳은 어디일까요?
- 벽지
- 욕실
- 장판
- 옷장
- 에어컨
- 베란다
가장 많이 발생하는 곳은 역시 가구 뒤편이나 장편 아래 등 사람의 눈에 잘 보이지 않고 어둡고 습도가 높은 곳입니다. 자주 눈에 보이는 곳은 청소도 가끔 하고 조금이라도 곰팡이가 발생하면 바로 조치가 되지만 눈에 보이지 않는 곳은 상태가 아주 심각해져야 비로소 보이기 시작합니다.
- 실리콘 곰팡이 제거방법
창틀이나 욕조, 주방에 있는 실리콘에 곰팡이가 생겼다면 휴지에 락스를 묻혀 실리콘에 붙여놓으면 됩니다. 락스각 균을 모두 죽이기 때문에 2~3시간 후에 휴지를 제거하면 하얗게 변한 실리콘을 볼 수 있다. 그 후 걸레로 한번 닦아주면 간단하게 없어집니다. 실리콘 곰팡이 제거방법은 간단합니다.



- 벽지 곰팡이 제거방법
벽지에 곰팡이가 생기게 되면 간단히 없애는 것은 어렵습니다. 벽지 곰팡이 제거방법은 우선 곰팡이가 생긴 벽지를 제거하는 것이 가장 확실한 방법입니다. 벽지 곰팡이는 곰팡이 제거제로 사용하고 청소를 해도 다시 번식하는 경우가 많습니다.
그래서 시중에 판매하는 곰팡이 제거제를 이용하여 한번 없애고 청소한 후 습도 관리를 하더라도 한번 얼룩진 벽지는 바뀌지 않습니다. 그래서 벽지 곰팡이는 우선 벽지를 제거한 후 곰팡이 제거제로 청소를 하고 습도 관리를 하면서 새로 벽지를 하는 것이 가장 확실한 방법입니다.






위 사진처럼 벽지를 제거해도 벽면에 얼룩진 것을 볼 수 있습니다. 벽지를 제거한 후 저 얼룩의 곰팡이 균을 제거한후 새로 벽지를 하고 습도 관리와 환기 관리를 잘해 주어야 합니다.
- 옷장 곰팡이 제거방법
옷장 곰팡이 제거는 우선 모든 옷을 빼고 휴지에 락스를 묻혀 잘 닦아 줍니다. 그리고 락스 냄새가 독한 편이기 때문에 하루 정도 말린 후 천연 탈최제를 한번 뿌린 후 다시 한번 말려줍니다.
그리고 옷을 다시 넣을 때는 신문지를 바닥에 깔고 넣으시면 습기 제거에 도움이 됩니다. 그리고 옷장은 제습제를 같이 사용하시는 것이 좋습니다. 옷장은 환기나 청소가 쉽지 않기 때문에 미연에 곰팡이 생성 환경을 차단하는 것이 좋습니다.
락스의 냄새가 독하기 때문에 옷장에 사용하시기가 어려운 분들은 시중에서 판매하는 제거제를 사용하셔도 됩니다. 물론 잘 검색하셔서 냄새가 덜나고 좋은 효능의 제거제를 선택하셔야겠습니다.
전 락스가 확실해서 락스를 쓰기는 하지만 사용 후 환기와 청소 그리고 천연 탈취제를 꼭 사용하고 있습니다.






'정보' 카테고리의 다른 글
| 법인설립 비용 (0) | 2020.08.03 |
|---|---|
| 장기수선충당금 (0) | 2020.08.01 |
| 임대차3법 시행 (0) | 2020.07.31 |
| 아파트 재산세 계산 (0) | 2020.07.31 |
| 주택자금조달 계획서 (0) | 2020.07.30 |
| 혼인관계증명서 (0) | 2020.07.29 |
| 기초생활수급자 혜택 (0) | 2020.07.29 |
| 청년 구직활동지원금 신청방법 (0) | 2020.07.28 |











































































